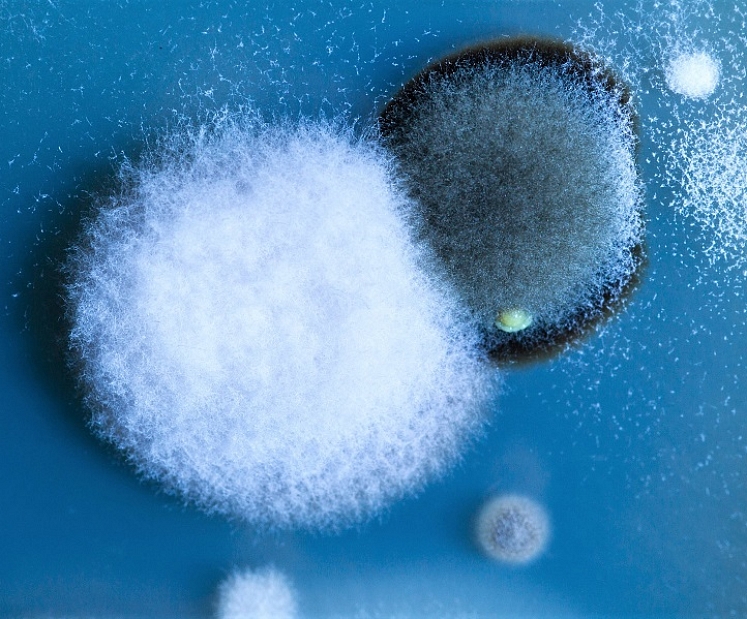
Vai kvarca lampa pret pelējumu ir iedarbīga?

Nedēļas tēma
Sienu gleznojumu unikalitāte

Sen jau aiz muguras tie laiki, kad vienīgā iespēja, kā izdaiļot sava mājokļa sienas bija jau ierastās tapetes. Šobrīd ir pieejamas neskaitāmas metodes kā ar izdomas un krāsu palīdzību var izdaiļot iekštelpas.
Aktuālie piedāvājumi
Izstāsti Latvijai
Atbild eksperti
Pusķieģeļa sienas: ko darīt lietas labā, lai pēc iespējas mazāk zaudētu telpu uz iekšu?
Labdien!Savā laikā opis mājai uzbūvēja piebūvi - kā nu līdzekļi un laiks atļāva. Tagad piebūvē vēlos izveidot virtuvi un viesistabu, bet problēma sākas tajā, ka piebūve ir pusķieģeļa biezuma, savilkta ar plakandzelzi gan stūros gan visā sienu garumā. Uz sienas (bez monolītās jostas un mūrlatas) balstās 2. stāva sijas un jumta spāres, vietām siena ir saplaisājusi, pieļauju, ka no palielinātas slodzes. Divām sienām, katra 5,5 m gara, plānoju no ārpuses izveidot papildu pamatus un koka karkasu 200 mm, uz kuru tad arī pārnest slodzi (šeit man interesētu pīrāgs, ņemot vērā, ka ķieģeļu siena būs iekšējā?). Bet lielākā problēma sākas ar garo sienu - 11.5m gara -, kas savieno abas iepriekšminētās, tā ir uz robežas ar kaimiņu teritoriju, tā kā no ārpuses baigi nesanāk neko sadarīt. Ko varētu darīt lietas labā, lai pēc iespējas mazāk zaudētu telpu uz iekšu?
Paldies!
Einārs Moļņiks
Vai katlam, kuram uzstādīts ir granulu deglis, ja nepieciešams iekurināt ar malku, deglis jāņem laukā?
Labdien!Vai katlam, kuram uzstādīts ir granulu deglis, ja nepieciešams iekurināt ar malku, deglis jāņem laukā? Vai var atstāt iekšā? Jo kaut kas notika un nestrādā...
Paldies!
Raitis Bērtiņš, SIA GIERSCH BALTIC valdes loceklis.
Kā bez jumta pārbūves atrisināt šo problēmu?
Labdien!Ieguvu mantojumā māju, kurai tika uzstādīts bleķa jumts pirms pāris gadiem, bet kaut kādu iemeslu pēc meistari nav uzlikuši plēvi apakšā. Tagad ir doma izbūvēt otro stāvu, bet nezinām, ko lai dara ar to jumtu, kad siltinās no iekšpuses. Raut nost jumtu - tās būs lielas izmaksas. Varbūt ir kāds veids, kā bez jumta pārbūves atrisināt šo problēmu?
Paldies!
Armands Liede, Dipl.Ing. Jumiķa amata meistars, SIA Jumti un Fasādes valdes priekšsēdētājs




